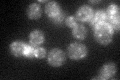
YCL001W
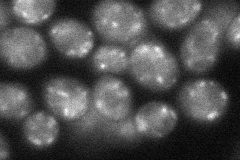
YCL001W
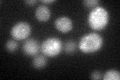
YCL001W
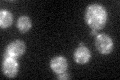
YCL001W

View description
Protein involved in retention of membrane proteins, including Sec12p, in the ER; localized to Golgi; functions as a retrieval receptor in returning membrane proteins to the ER
Localization:
Intensity:
Fold change:
Significance:
-
C’ GFP library in SD
punctate31.04 -
N' NOP1pr-GFP in SD

punctate140.782 -
N' TEF2pr-mCherry in SD

vacuole148.378 -
N' NATIVEpr-GFP in SD

ER,punctate71.4248 -
N' TEF2pr-VC and Cyto-VN in SD
punctate46.1398 -
C’ GFP library in SD+DTT
punctate25.10.8No -
C’ GFP library in SD+H2O2
punctate32.551.04No -
C’ GFP library in Starvation Media

punctate18.460.59Yes -
C’ GFP library on the background of Pup2-DaMP

vacuole -
C’ GFP library on the background of CCT mutant

punctate30.97420.997536No
